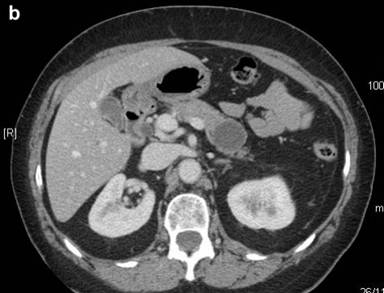

CASE REPORT
JOP. J Pancreas (Online) 2013 Nov 10; 14(6):657-660.
Squamoid Cyst of Pancreatic Ducts: A Challenging Differential Diagnosis among Benign Pancreatic Cysts
Anna Caterina Milanetto1, Loredana Iaria2, Rita Alaggio2, Sergio Pedrazzoli1, Claudio Pasquali1
1Fourth Surgical Clinic and 2Pathology, University of Padua. Padua, Italy
ABSTRACT
Context In the last years, cystic pancreatic lesions are often detected when clinically silent, because of the wider use of diagnostic imaging techniques. First described by Othman in 2007, “squamoid cyst of pancreatic ducts” represents a cystic dilation of ducts, lined by non-keratinized squamous epithelium. We report the first case of squamoid cyst of pancreatic ducts in Italy. Case report A 68-year-old woman presented a cystic lesion (4 cm) of the pancreatic tail as incidental finding at MRI. It had a thickened wall, no internal septa and no communication with the Wirsung duct were detected. A CT scan showed a lamellar calcification on its posterior wall. A 18F-FDG-PET was negative. Blood tests were normal, including CEA and CA 19-9. We performed a spleen-preserving distal pancreatectomy. Histology showed a unilocular cyst, with serous fluid and a fibrous wall, with multilayered epithelium without cytological atypias. Immunohistochemistry showed CK 7 positive and CK 5 negative. The patient is still alive and without disease after 42 months of follow-up. Conclusions In the English literature only seven cases resected for this cyst type have been reported. No preoperative test can achieve a definitive diagnosis, so surgical resection remains the treatment of choice in order to exclude malignancy. However, after intraoperative frozen section, a limited pancreatic resection can be performed.
INTRODUCTION
In the last years the detection of pancreatic cystic lesions has increased, because of the wide diffusion of high-resolution diagnostic imaging techniques. Therefore, cystic and intraductal lesions of the pancreas are detected even if clinically silent and represent an important category of patients with a challenging differential diagnosis.
Recently, a new type of cystic pancreatic lesion has been recognized, which represents a cystic dilation of ducts, lined by non-keratinized squamous epithelium: it has been called “squamoid cyst of pancreatic ducts”. It is very important to differentiate this benign cystic lesion from mucinous cystic neoplasms (MCNs) and intraductal papillary mucinous neoplasms (IPMNs), which are potentially malignant cystic tumors.
We report the first case of squamoid cyst of pancreatic ducts in Italy.
CASE REPORT
During routine follow-up for a non-functioning left adrenal adenoma (2.0 cm in diameter), a 68-year-old woman underwent a cholangio-Wirsung magnetic resonance and a 4.0 cm cystic unilocular lesion was detected in the pancreatic tail. The cyst had a thickened wall, but not internal septa (Figure 1a). No communication was found with the main pancreatic duct, which was not dilated.
Then, abdominal computed tomography (CT) performed six months later showed that the cystic lesion did not increase in size, but had a 12.0 mm lamellar calcification on the posterior wall and impressed the left renal vein, without any signs of invasion of the surrounding tissues (Figure 1bc). The cystic lesion had no increased tracer uptake at 18F-FDG-positron emission tomography (PET). The patient had no symptoms related to the pancreatic lesion and blood tests were all normal. Serum carbohydrate antigen 19-9 (CA 19-9) and carcinoembryonic antigen (CEA) levels were normal.

|
Figure 1. a. The pancreatic tail cyst at MRI scan. b. c. CT scan showing a 4 cm cystic fluid mass arising from the tail of the pancreas, with well defined margins and a lamellar calcification on the posterior wall. |
Because of the size of the lesion and on the suspicion of a MCN, the patient underwent laparotomy. Intraoperatively, the cystic lesion (4.0 cm in diameter) was arising from the pancreatic body. There were not any infiltrations of the surrounding tissues or peripancreatic lymph-node swelling. Therefore, we performed a spleen-preserving distal pancreatectomy, with splenic vessels preservation. The frozen section histology of the surgical margin was negative for malignancy.
During the post-operative course, the patient had abdominal pain due to a peripancreatic fluid collection, suggesting a low output pancreatic fistula. She was treated with a percutaneous drainage and the catheter was removed after one month. She is still alive and well after forty-two months of follow-up. She is asymptomatic, with mild diabetes and normal exocrine pancreatic function. The last CT scan performed did not show disease relapse and exocrine pancreatic tumor markers (CEA, CA 19-9) were negative.
Macroscopically, the cystic lesion of the pancreas (3.0x2.0 cm) was unilocular, with smooth internal and external surfaces and contained serous clear fluid. Histological examination of the pancreatic parenchyma section revealed the presence of a dilated main pancreatic duct and a cyst with a fibrous wall. The cyst was lined by multilayered epithelium, without cytological atypias. It was surrounded by normal pancreatic parenchyma and by fat tissue, without any signs of pancreatitis. No tall columnar mucinous cells were identified. No associated lymphoid or splenic tissues were present. The lesion did not display ovarianlike stroma (Figure 2ab). The epithelium of the cyst reacted positively with cytokeratin 7 (CK 7, expression profile of pancreatic ducts), but negatively with CK 5 in immunohistochemistry.


|
Figure 2. Squamoid cyst of pancreatic ducts is lined by non-keratinized squamous epithelium (hematoxylin-eosin stain; a. 5x; b. 10x). |
DISCUSSION
First described by Othman et al. [1] in 2007, squamoid cyst of pancreatic ducts has morphologic, immunophenotipic and clinical characteristics that distinguish it from other cystic lesions in this organ. In the English literature, only seven cases resected for this cyst type have been reported [1, 2]. Othman et al. [1] reported on six cystic lesions that resulted from unilocular cystic dilatation of the ducts and had variable linings, ranging from attenuated, flat, non-stratified squamous, to transitional and stratified squamous epithelium, without a cornified layer or parakeratosis. No tall-columnar mucinous cells or acinar cells were evident. The wall of the cyst was composed of a thin band of fibrous tissue, with focal islets or tributary ducts, confirming the intraductal nature of the process. There was no evidence of pancreatitis (fibrosis or inflammation) in the surrounding tissue. Immunohistochemical analysis demonstrated that MUC1 and MUC6 (markers of intercalated duct cells) were expressed in the cyst epithelium and the inner layer expressed nuclear p63 (marker of squamous/transitional epithelium). Cytokeratin expression profiles were that of pancreatic ducts, showing CK 7 and CK 19 positivity, but lacking CK 20.
In 2009, Kurahara et al. [2] reported on the first case of squamoid cyst of pancreatic ducts in Japan, a cystic lesion lined by squamous epithelium expressing MUC1, MUC6 and involucrin (marker of terminal differentiation in stratified squamous epithelia).
In these cases, macroscopic and microscopic findings showed that squamoid cyst of pancreatic ducts constitutes a cystic dilatation of the ducts, with a squamous transformation of epithelial cells. Immunohistochemistry confirmed the squamous/transitional nature of the epithelial lining and suggested a relationship with the centroacinar/intercalated duct system [2].
Other types of squamous-lined cysts of the pancreas have been described: lymphoepithelial cysts, dermoid cysts and accessory-splenic epidermoid cysts. Lymphoepithelial cysts are well-delineated cysts that may be multilocular (60%) or unilocular (40%) and they are characterized by stratified squamous epithelium surrounded by a bound of mature lymphoid tissue with well-formed germinal centers [3]. Dermoid cysts of the pancreas are very rare. They are also called cystic teratomas of the pancreas and their wall may contain sebaceous glands, hair, lymphoid tissue and even inflammatory cells [4]. The third type of pancreatic squamous-lined cyst is the epidermoid cyst arising in intrapancreatic accessory spleen. They are lined by attenuated squamous cells, usually non-stratified, surrounded by normal-appearing splenic tissue [5]. These cystic lesions of the pancreas are thought to be all benign.
From a clinical point of view it is very important to distinguish squamoid cyst of pancreatic ducts from MCNs and IPMNs, that may develop into invasive carcinoma.
MCNs are characterized by uni- or multi-locular cysts located mainly in the body-tail of the pancreas, that do not communicate with the ductal system. The macrocystic multilocular pattern usually appear on CT scan as a sharply defined mass surrounded by a variably thickened wall, with cystic spaces delimited by thin septa and calcifications in the wall of the cyst. The presence, features and distribution of internal septa and the main pancreatic duct are seen better on T2-weighted magnetic resonance images. The macrocystic unilocular pattern is less specific and it is not easy to differentiate it from any other kind of pancreatic cystic mass. These tumors have the potential to turn malignant in 6-36% of cases [6]. From a radiological point of view, a thickened wall, the presence of papillary proliferations arising from the wall or septa, the evidence of peripheral calcifications and invasion of the surrounding vascular structures are considered signs of malignity [7]. The tumor is lined by columnar mucin-producing cells overlying an ovarian type stroma.
IPMNs are the most important precursor lesions of ductal pancreatic cancer. They grow in the main duct or branch ducts of the pancreas, produce mucin and have differentiated papillary features. In branch-duct type IPMNs a malignant tumor is found in 6-46%, and in main-duct IPMNs in 57-92% [8]. Endoscopic ultrasonography is a useful diagnostic modality in cystic pancreatic tumors and the typical feature for IPMN is papillary growth in the pancreatic ducts. On CT scan IPMNs appear as a diffusely distended pancreatic duct with mucinous filling defects and grape-like, cystic, space-occupying lesions [9]. Magnetic resonance imaging can also expose the pancreatic duct system and the cystic lesions in detail and seems to be superior to CT to characterize IPMNs [9].
According to the recent international consensus guidelines for the management of IPMN and MCN of the pancreas by Tanaka et al. [10], all cysts with “high-risk stigmata” should be resected and resection is recommended for all surgically fit patients with main duct-IPMN and with MCN.
The six cases reported by Othman et al. [1] were all resected based on the suspicion of mucinous tumors. The Whipple procedure was performed in four cases, subtotal pancreatectomy was performed in one case and distal pancreatectomy was performed in one case. In the case reported by Kurahara et al. [2] a MCN was suspected, so the patient underwent a central pancreatectomy. We also diagnosed our case as MCN of the body of the pancreas and performed a spleen-preserving distal pancreatectomy. In our case, the lesion did not grow in a six-month time interval before operation, but had a peripheral lamellar calcification on the wall, so the chance to be a premalignant lesion could not be excluded. Therefore, surgical resection was indicated, considering the patient’s age and comorbidity, the surgical risk and the location of the lesion.
In conclusion, these cystic lesions lined by squamous epithelium are rare. Squamoid cyst of pancreatic ducts has been proposed only recently as a distinct pathologic lesion and should be considered as benign. Surgical resection is the treatment of choice of these cystic lesions, despite their benign nature, in order to exclude malignancy.
There is no preoperative test that can achieve a definitive diagnosis, so surgical resection is required. Endoscopic ultrasonography and fine-needle aspiration cytology may avoid unnecessary surgery if squamous epithelium is found in the cytologic sample. However, after an intraoperative frozen section, a limited pancreatic resection can be performed.
Received August 13th, 2013– Accepted September 26th, 2013
Keywords Cysts; Pancreas; Pancreatic Neoplasms
Conflicts of interest The authors have no conflicts to disclose
Correspondence
Anna
Caterina Milanetto
Clinica Chirurgica IV
University of Padua
Via Giustiniani, 2
35127 Padua
Phone: +39-049.821.8845
Fax: +39-049.821.8821
E-mail: ac.milanetto@email.it
References
1. Othman M et al, Squamoid cyst of pancreatic ducts: a distinct type of cystic lesion in the pancreas. Am J Surg Pathol. 2007; 31: 291-297 [PMID: 17255775]
2. Kurahara H et al, A case of squamoid cyst of pancreatic ducts. Pancreas. 2009; 38: 349-351 [PMID: 19307935]
3. Adsay NV et al, Squamous-lined cysts of the pancreas: lymphoepithelial cysts, dermoid cysts (teratomas), and accessory-splenic epidermoid cysts. Semin Diagn Pathol. 2000; 17: 56-65 [PMID: 10721807]
4. Fernandez CJM et al, Dermoid cyst of the pancreas: a rare cystic neoplasm. Hepatogastroenterology. 1998; 45: 1874-1876
5. Kanazawa H et al, Epidermoid cyst in an intrapancreatic accessory spleen: a case report. J Hepatobiliary Pancreat Surg. 2004; 11: 61-63 [PMID: 15754048]
6. Testini M et al, Management of mucinous cystic neoplasms of the pancreas. World J Gastroenterol. 2010; 16: 5682-5692 [PMID: 21128317]
7. Salvia R et al, Pancreatic cystic tumors. Minerva Chir. 2004; 59: 185-207 [PMID:15238892]
8. Tanaka M et al, International consensus guidelines for management of Intraductal Papillary Mucinous Neoplasms and Mucinous Cystic Neoplasms of the pancreas. Pancreatology. 2006; 6: 17-32 [PMID: 16327281]
9. Grützmann R et al, Intraductal Papillary Mucinous Neoplasia (IPMN) of the pancreas. Dtsch Arztebl Int. 2011; 108: 788-794 [PMID: 22163260]
10. Tanaka M et al, International consensus guidelines 2012 for the management of IPMN and MCN of the pancreas. Pancreatology. 2012; 12: 183-197 [PMID: 22687371]